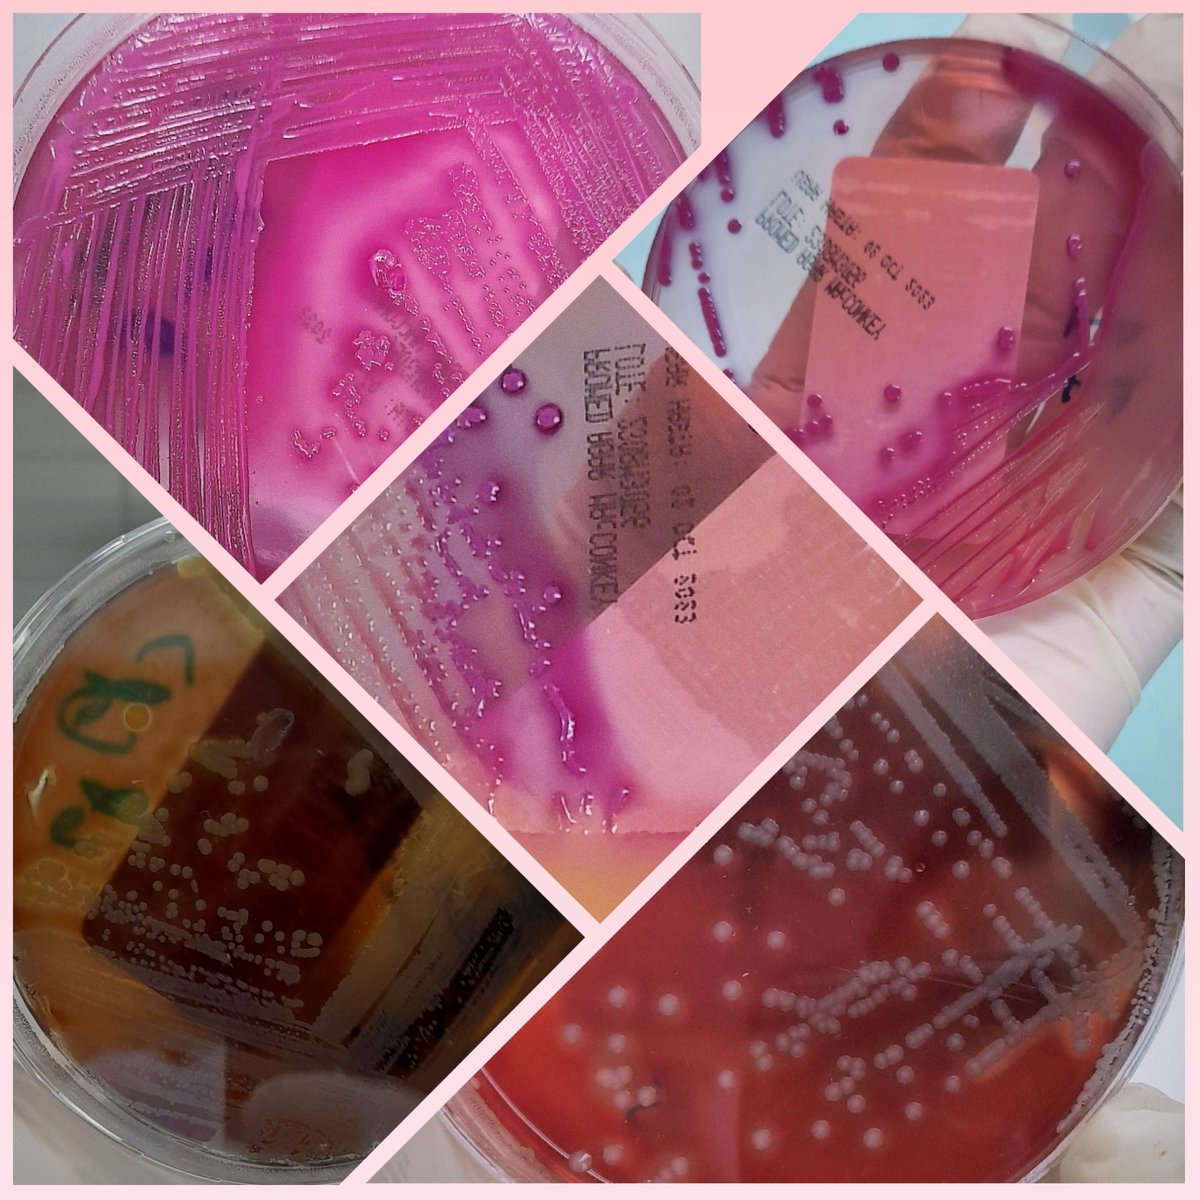
Notesoskr's tweet image. Microbiologia termino siendo una de mis rotaciones favoritas🤯. Algo que no pensaba al inicio xd.

#microbiology
#biomedicina
#sciencelaboratory
#science

#sciencelaboratory resultados da pesquisa
👃🎈 Nuestros alumnos de P5 han realizado en #ScienceLaboratory modelos funcionales del aparato respiratorio para entender mucho mejor la acción del diafragma. Un proyecto muy completo, en que se integran conocimientos de física, biología y tecnología. #EuropaEsMiColegio
🌱💡 En #ScienceLaboratory, los alumnos de P6 han preparado unos experimentos de larga duración para descubrir los efectos de la luz en las plantas. La espera ha dado sus frutos y han observado fenómenos como el fototropismo. #EuropaEsMiColegio


🌿💦 Los alumnos de P5 han llevado a cabo en #ScienceLaboratory unos experimentos para comprender mejor cómo las plantas hacen circular por su interior los nutrientes que absorben por las raíces gracias a la transpiración de agua que ocurre en sus hojas. #EuropaEsMiColegio

👩🔬⚛️🧪Estudiamos las propiedades de la materia en #ScienceLaboratory. Nuestros alumnos de P5 y P6 han medido masa, volumen y densidad de diferentes sustancias para luego compararlos y extraer conclusiones que les han permitido comprender mejor los conceptos. #EuropaEsMiColegio

Inaugurated a New #ScienceLaboratory at famed #RPSchool in Nagbal Ganderbal. It is great to see our children taking keen interest in Science and Technology. Modiji led govt implemented NEP has paved ways for holistic development of our kids. Nourishing scientific temper in our…

NEW ENERGY ZERO 本日、最終日です! 17時までやってます。 遊びに来てくださ~い。 #Newenergy #ニューエナジー #ScienceLaboratory #DrMaayaLabo

NEW ENERGY ZERO 本日一般人の入場、17時からでーす! 20時まで会場におりま~す。 お待ちしております。 #NewEnergyZero #ニューエナジー #ScienceLaboratory

कक्षा 9 की छात्राओं ने खाद्य पदार्थ (आलू) में स्टार्च के उपस्थिति की जाँच की। आवश्यक उपकरण:- खाद्य पदार्थ (आलू), लोहे का स्टैंड, आसुत जल, परखनली (Boiling Tube) , स्प्रीट लैंप, चाकू, आयोडीन का विलयन #Learningbydoing #ScienceLaboratory @BiharEducation_ @teachersofbihar
Nuestros alumnos descubren en #ScienceLaboratory lo fascinante de la #ciencia, esta vez disfrutando de una clase especial sobre #Halloween Science! 🎃👻🐍 europaschool.org #Aprender #Descubrir #EuropaEsMiColegio
Science Laboratoryさんと一緒にPOP UPです! 阪神梅田本店です。お立ち寄りいただけると幸いです。 期間:3月30日(水)-4月5日(火) 10:00-20:00 場所:大阪阪神梅田本店3F ウェルネスビューティーワールド フロアイベントウエスト #阪神梅田本店 #ScienceLaboratory #DrMaayaLabo

Science laboratory day of Grade 3. 📖🧫🧪⚗️🧲🧬🔬 #sciencelaboratory #grade3 #fingerprints #teacher #education #learning #school #cambridge #motivation #students #study #covid #student #children #pakistan #teachers #knowledge #kids #teaching #inspiration




ತುಮಕೂರು ವಿಶ್ವವಿದ್ಯಾನಿಲಯದಲ್ಲಿ ರಾಷ್ಟ್ರೀಯ ಉಚ್ಚ ಶಿಕ್ಷ ಅಭಿಯಾನದ (ರೂಸಾ - RUSA) ಅನುದಾನದಡಿ 1.20 ಕೋಟಿ ವೆಚ್ಚದಲ್ಲಿ ನಿರ್ಮಾಣಗೊಂಡಿರುವ ನೂತನ ವಿಜ್ಞಾನ ಪ್ರಯೋಗಾಲಯ ಕಟ್ಟಡವನ್ನು ಶ್ರೀ ವೀರೇಶಾನಂದ ಸರಸ್ವತಿ ಸ್ವಾಮೀಜಿಗಳೊಂದಿಗೆ ಉದ್ಘಾಟಿಸಲಾಯಿತು. #tumkuruniversity #sciencelaboratory

Will you be attending the @BSABoarding Annual Conference for Headson the 2nd / 3rd May.? Visit our stand to find out more about our bespoke #boarding accommodation, #sciencelaboratory & #teachingwall furniture. #iloveboarding

Science experiments are one the most fun-filled practice way to learn complicated science concepts more simply. In NGA, students observed and did science experiments themselves at our well-established “Science Laboratory" our life! 🔍#sciencelaboratory #scienceexperiment


विज्ञान प्रयोगशालाले थपिदिएको हौसला #ScienceLaboratory #research #Jumla #science #kantipurshorts #Sunsilk
Without laboratories, men of science are like soldiers without arms. . iimtindia.net 9717015300, 9911009144 . #IIMTCampus #ScienceLaboratory #EngineeringCollege #AKTUadmissiongreaterNoida #MCAadmission2021 #Btechadmission2021 #BBA #BCA #BJMC #Law #LLBadmission

The Association for Science Education Feature SpaceStation splusb.co.uk/the-associatio… #labfurniture #sciencelaboratory

बर्खास्त बीएडधारी शिक्षकों के साथ सरकार ने किया न्याय : सहायक शिक्षक विज्ञान प्रयोगशाला के पद पर होगा समायोजन, CM साय के आश्वासन के बाद 126 दिनों तक चले आंदोलन को शिक्षकों ने किया था समाप्त #b_edteacher #assistantteacher #sciencelaboratory @vishnudsai lalluram.com/the-government…
lalluram.com
बर्खास्त बीएडधारी शिक्षकों के साथ सरकार ने किया न्याय : सहायक शिक्षक विज्ञान प्रयोगशाला के पद पर...
रायपुर. साय सरकार ने बर्खास्त बीएडधारी शिक्षकों के समायोजन का फैसला लिया है. इन शिक्षकों को सहायक शिक्षक विज्ञान प्रयोगशाला के पद पर समायोजित किया जाएगा.
Another video to view later tonight. #ScienceLaboratory #Wolves youtu.be/Ar0zgedLyTw?fe…

youtube.com
YouTube
They Didn't Make Dire Wolves, They Made Something…Else
instagram.com/reel/DIOTN3gv5… Heartbreaking cruel only a deviant could inflict such pain and suffering #peta #ScienceLaboratory
instagram.com
AboliciónVivisección (@abolicion.viviseccion) • Instagram reel
AboliciónVivisección (@abolicion.viviseccion) • Instagram reel
Inaugurated a New #ScienceLaboratory at famed #RPSchool in Nagbal Ganderbal. It is great to see our children taking keen interest in Science and Technology. Modiji led govt implemented NEP has paved ways for holistic development of our kids. Nourishing scientific temper in our…

সিটি কলেজ-আইডিয়াল কলেজ শিক্ষার্থীদের সংঘর্ষ - Nagorik News nagorik.news/city-college-i… #Dhaka #sciencelab #sciencelaboratory #DhakaCityCollege #idealcollege #Clash #Banglanews #Bangladesh
कक्षा 9 की छात्राओं ने खाद्य पदार्थ (आलू) में स्टार्च के उपस्थिति की जाँच की। आवश्यक उपकरण:- खाद्य पदार्थ (आलू), लोहे का स्टैंड, आसुत जल, परखनली (Boiling Tube) , स्प्रीट लैंप, चाकू, आयोडीन का विलयन #Learningbydoing #ScienceLaboratory @BiharEducation_ @teachersofbihar
विज्ञान प्रयोगशालाले थपिदिएको हौसला #ScienceLaboratory #research #Jumla #science #kantipurshorts #Sunsilk
Students of DU affiliated colleges demand univ status, block Science Lab crossing in Dhaka newagebd.net/post/country/2… #newagebd #newage #sciencelaboratory #DUaffiliatedcollege #Bangladesh #Dhaka #StudentProtests
ગૃહ વિભાગ હસ્તકની ન્યાય સહાયક વિજ્ઞાન પ્રયોગશાળામાં વિવિધ નમૂનાઓના પૃથ્થકરણ અને તાલીમ માટેની ફીના નવા ધોરણો જાહેર કરાયા #science #education #Sciencelaboratory
future aircraft technicians. #flyingsciencelab #sciencelaboratory #ScienceMission #NASA #palmdale #idahostateuniversity #Idaho #pocatello #researchcenter #dc8aircraft #drdemola
Integration of Virtual Anatomy Labs in Coastal District Medical Colleges #virtuallabs #scienceandtechnology #sciencelaboratory #newskarnataka newskarnataka.com/karnataka/coas…
NEW ENERGY ZERO 本日、最終日です! 17時までやってます。 遊びに来てくださ~い。 #Newenergy #ニューエナジー #ScienceLaboratory #DrMaayaLabo

Inaugurated a New #ScienceLaboratory at famed #RPSchool in Nagbal Ganderbal. It is great to see our children taking keen interest in Science and Technology. Modiji led govt implemented NEP has paved ways for holistic development of our kids. Nourishing scientific temper in our…

NEW ENERGY ZERO 本日一般人の入場、17時からでーす! 20時まで会場におりま~す。 お待ちしております。 #NewEnergyZero #ニューエナジー #ScienceLaboratory

🌱💡 En #ScienceLaboratory, los alumnos de P6 han preparado unos experimentos de larga duración para descubrir los efectos de la luz en las plantas. La espera ha dado sus frutos y han observado fenómenos como el fototropismo. #EuropaEsMiColegio


🌿💦 Los alumnos de P5 han llevado a cabo en #ScienceLaboratory unos experimentos para comprender mejor cómo las plantas hacen circular por su interior los nutrientes que absorben por las raíces gracias a la transpiración de agua que ocurre en sus hojas. #EuropaEsMiColegio

👩🔬⚛️🧪Estudiamos las propiedades de la materia en #ScienceLaboratory. Nuestros alumnos de P5 y P6 han medido masa, volumen y densidad de diferentes sustancias para luego compararlos y extraer conclusiones que les han permitido comprender mejor los conceptos. #EuropaEsMiColegio

Will you be attending the @BSABoarding Annual Conference for Headson the 2nd / 3rd May.? Visit our stand to find out more about our bespoke #boarding accommodation, #sciencelaboratory & #teachingwall furniture. #iloveboarding

Science Laboratoryさんと一緒にPOP UPです! 阪神梅田本店です。お立ち寄りいただけると幸いです。 期間:3月30日(水)-4月5日(火) 10:00-20:00 場所:大阪阪神梅田本店3F ウェルネスビューティーワールド フロアイベントウエスト #阪神梅田本店 #ScienceLaboratory #DrMaayaLabo

Without laboratories, men of science are like soldiers without arms. . iimtindia.net 9717015300, 9911009144 . #IIMTCampus #ScienceLaboratory #EngineeringCollege #AKTUadmissiongreaterNoida #MCAadmission2021 #Btechadmission2021 #BBA #BCA #BJMC #Law #LLBadmission

Microbiologia termino siendo una de mis rotaciones favoritas🤯. Algo que no pensaba al inicio xd. #microbiology #biomedicina #sciencelaboratory #science
Science experiments are one the most fun-filled practice way to learn complicated science concepts more simply. In NGA, students observed and did science experiments themselves at our well-established “Science Laboratory" our life! 🔍#sciencelaboratory #scienceexperiment


Science laboratory day of Grade 3. 📖🧫🧪⚗️🧲🧬🔬 #sciencelaboratory #grade3 #fingerprints #teacher #education #learning #school #cambridge #motivation #students #study #covid #student #children #pakistan #teachers #knowledge #kids #teaching #inspiration




ATNS launches 16th ICT and Science Laboratory in Brandfort, Free State Province ow.ly/pqYf30qngXK #ArriveAlive #ICT #ScienceLaboratory @ATNSSA

The Association for Science Education Feature SpaceStation splusb.co.uk/the-associatio… #labfurniture #sciencelaboratory

Something went wrong.
Something went wrong.
United States Trends
- 1. Davis Mills 4,030 posts
- 2. Texans 27.8K posts
- 3. Josh Allen 12.4K posts
- 4. #MissUniverse 109K posts
- 5. Ray Davis 1,863 posts
- 6. #TNFonPrime 1,769 posts
- 7. Taron Johnson N/A
- 8. Christian Kirk 2,975 posts
- 9. James Cook 4,638 posts
- 10. Nico Collins 1,560 posts
- 11. Cole Bishop N/A
- 12. Sedition 244K posts
- 13. Jayden Higgins N/A
- 14. Maxey 3,063 posts
- 15. Shakir 3,620 posts
- 16. Cam Lewis N/A
- 17. #Isles 2,190 posts
- 18. Will Anderson 2,967 posts
- 19. #htownmade 1,685 posts
- 20. #BUFvsHOU 1,942 posts
































